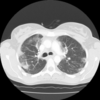
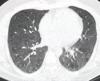

RA ILD
Tx that will address both
Steroids
Rituximab
MMF
RA ILD
Tx for lungs only
(ie joint haven’t presented yet but CCP +ve)
Cyclophosphamide
Azothiaprine
RA ILD
Tx joints alone
Hydrochloroquinine
Sulfasalazine
When does methotrexate pneumonitis occur
6-12
Is methotrexate for RA more likely to cause pneumonitis than for other conditions
Yes
Features of anti synthetase syndrome
Myositis
ILD
Joint pain and inflammation
ANTIBODY POSITIVE!!
Consolidation GG
Subpleural
Wedge shaped
Centrilobular
Moves location
COP

What does lymphopaenia show in sarcoid
Disease activity
What % of non-IPF ILDs will progress
18-32%
What’s the definition of Progressive Pulmonary Fibrosis
2 of 3:
- worsening resp sx
- physiological evidence of progression
- decline FVC 5% + predicted within 1 year FU
- decline in DCLO 10%+ within 1 year FU - Radiological evidence progression:
- increased extent/severity bronchiectasis
- new GGO with traction bronchiectasis
- new fine reticulation
- increased extent/coarseness of reticular abnormality
- new/increased honeycombing
- increased lobar volume loss
NSIP prognosis vs IPF prognosis
NSIP has better prognosis, more steroid responsive
Which age pts tend to get NSIP
40-50
Timescale of NSIP onset
0.5 - 3 years
Do NSIP pts get clubbing
Small amount yes
HRCT Findings NSIP

GG, basal predominant
+- reticulation and traction bronchiectasis
Homogenus
No honeycombing
Subpleural sparing highly specific
PFTs in NSIP
restrictive
impaired gas transfer in 50%
BAL in NSIP
lymphocytosis
Lung biopsy often needed to confirm dx
NSIP histology 1,2,3
NSIP 1 - cellular
NSIP 2 - mixed
NSIP 3 - fibrotic
Steroid dose for NSIP
0.5mg/kg pred
azathioprine/MMF might be needed if not responsive/suitable for steroids
Which type of NSIP has better prognosis
cellular
5 year survival fibrotic NSIP
50%
What is Cryptogenic Organising Pneumonia
Disease of unknown cause
plugging of alveolar spaces with granulation tissue
can extend up to bronchioles
Which patients get COP
Non smokers
Around 55
Causes COP
Cryptogenic infection
Drug reaction/radio
CTD
Diffuse alveolar damage
IBD
Haem malignancy
Bone marrow transplant
Lung malignancy/airway obstruction
Pulmonary infarct